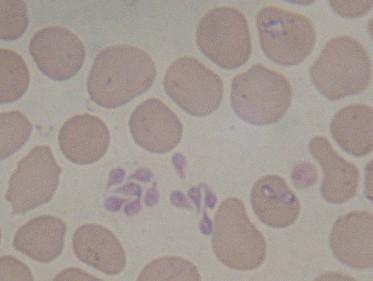

Santé du dogue allemand : la piroplasmose
Définition
La piroplasmose ou babésiose est une maladie qui tue encore de nombreux chiens chaque année. Cette maladie est due à un parasite protozoaire de type Babesia qui pénètre à l'intérieur des globules rouges du sang et provoque leur éclatement.
Il en résulte une anémie (chute importante du taux de globules rouges dans le sang). Les globules rouges détruits finissent par provoquer une intoxication du foie et des reins.
Un chien atteint de piroplasmose n'est pas contagieux. Il ne transmet pas la maladie à d'autres chiens, à d'autres animaux ou à l'homme.
Transmission
La transmission de cette maladie se fait uniquement par les tiques. Cependant, toutes les tiques ne sont pas porteuses de piroplasmes.
Pour aspirer le sang du chien, la tique pique le chien de son rostre et lui injecte une salive anticoagulante qui contient les parasites de la piroplasmose.
Symptômes
Les premiers symptômes apparaissent 6 à 8 jours après la piqure de tique porteuse de piroplasmes. On observe :
- un air abattu
- un refus de la nouriture
- des vomissements
- de la fièvre
- une urine anormalement colorée (orange, rouge, ou marron foncé)
- les muqueuses de l'oeil et des babines très pâles
- une réspiration accélérée
- un pouls faible et rapide
- une perte de poids
Diagnostic
Le seul moyen est de prélever un peu de sang du chien et de l'examiner sous microscope afin d'y détecter la présence des parasites dans les globules rouges.
Sang d'un chien atteint de piroplasmose
© François Bagaïni
Traitement
Suivant le stade d'évolution de la maladie, le traitement consistera à faire :
- des injections pour détruire le parasite
- des perfusions afin de réhydrater l'animal et lutter contre les complications hépatiques et rénales
- des transfusions afin de pallier à la destruction des globules rouges.
Démarré rapidement, le traitement est efficace. Certains chiens conservent cependant des séquelles. Les complications peuvent être graves et souvent néfastes au chien. Il est donc impératif de déceler l'apparition des symptômes et de détecter la maladie le plus rapidement possible.
Prévention
La prévention peux se faire à 2 niveaux :
Par anti-parasitaires
Le meilleur moyen de prévenir la piroplasmose est dempêcher la tique de piquer l'animal. Il faut donc choisir un anti-parasitaire efficace. On en trouve sous forme de colliers, de pulvérisateurs ou encore sous forme de pipettes. Lanti-parasitaire doit être utilisé même sur les animaux vaccinés.
Par vaccination
Le vaccin ne garantit pas une protection à 100%. Il est surtout efficace sur les jeunes chiens qui n'ont jamais été contaminé par le piroplasme. Pour les chiens adultes, il nest malheureusement pas efficace totalement mais il diminue significativement le risque de maladie.
Haut de la page

